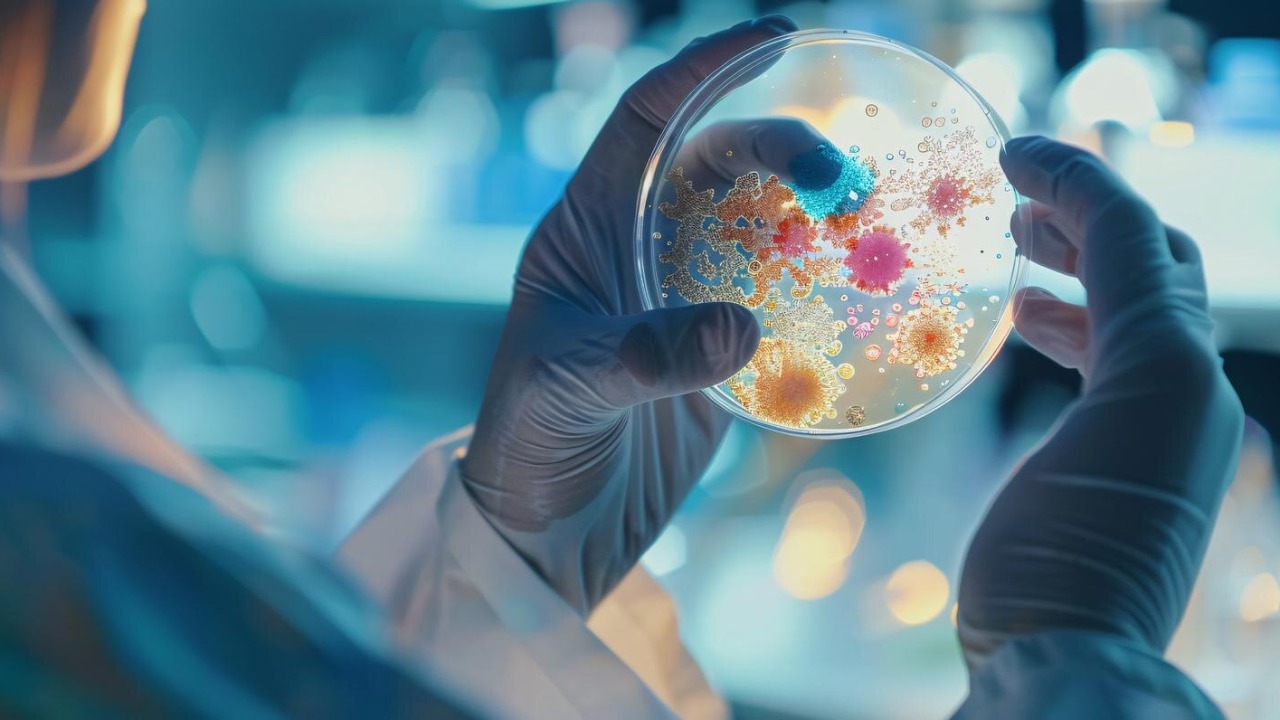
Image by Freepik

The intricate relationship between bacterial infections and cancer risk has garnered increasing attention in the scientific community. Recent studies focus on the potential cancer risk associated with a common yet elusive bacterial infection, raising questions and prompting further investigation.
Understanding the Bacterial Culprit
One of the bacteria currently under scrutiny is Helicobacter pylori, a microorganism that inhabits the human stomach. This bacterium is incredibly prevalent, with estimates suggesting that it infects more than half of the global population. Known for causing conditions such as peptic ulcers and gastritis, H. pylori thrives in the acidic environment of the stomach, adapting unique mechanisms to survive and persist. Despite its widespread presence, many who carry the bacterium remain asymptomatic, making detection particularly challenging.
The elusive nature of H. pylori stems from its ability to remain dormant for extended periods, often undetected until significant health complications arise. Traditional diagnostic methods, such as breath, blood, and stool tests, sometimes fail to detect the bacterium, especially in asymptomatic individuals. This stealthy behavior not only complicates diagnosis but also contributes to the bacterium’s potential role in more severe health outcomes, including its suspected link to cancer.
Beyond its suspected connection to cancer, H. pylori infection has well-documented impacts on human health. It is a major cause of peptic ulcers and chronic gastritis, conditions that can lead to severe discomfort and complications if left untreated. These diseases highlight the importance of understanding and managing H. pylori infections, even before considering their potential role in cancer development.
The Link Between Infection and Cancer
Recent research has intensified the investigation into the potential connection between H. pylori infection and cancer. Studies have suggested a correlation between chronic infection with this bacterium and an increased risk of gastric cancer, one of the most lethal forms of cancer worldwide. This correlation has sparked interest in understanding the biological pathways through which H. pylori might contribute to cancerogenesis.
Biologically, H. pylori can induce chronic inflammation in the stomach lining, a condition known as chronic atrophic gastritis, which is a recognized precursor to gastric cancer. The bacterium’s ability to interfere with cellular processes, such as inhibiting apoptosis and promoting unchecked cell proliferation, further elucidates its potential role in tumorigenesis. Additionally, the bacterium’s production of cytotoxins and its impact on the host’s immune response highlight its multifaceted influence on cancer development.
In practical terms, the implications of this research are significant. For example, a long-term study in Japan observed that individuals infected with H. pylori had a markedly higher incidence of gastric cancer compared to those who were uninfected. These findings underscore the importance of early detection and intervention in managing the risks associated with this common infection.
Diagnostic Challenges and Innovations
The current methods for diagnosing H. pylori infection are not without limitations. Non-invasive tests, such as the urea breath test, can sometimes yield false negatives, especially in individuals who have recently used antibiotics or proton pump inhibitors. Even more invasive methods, such as endoscopy with biopsy, can miss the infection if the bacteria are not uniformly distributed across the gastric mucosa.
In response to these challenges, advances in diagnostic technology are emerging. Innovations such as high-throughput sequencing and more sensitive antigen detection methods are being explored to enhance accuracy and reliability. Furthermore, research into point-of-care testing devices aims to provide rapid, on-site diagnosis, which could be particularly beneficial in resource-limited settings.
Early diagnosis of H. pylori infection is crucial, not only to address immediate health concerns like ulcers but also to mitigate the potential long-term cancer risk. By identifying and treating the infection promptly, healthcare providers can potentially reduce the incidence of related gastric malignancies, highlighting the importance of advancing diagnostic capabilities.
Implications for Public Health
The potential link between H. pylori infection and cancer necessitates a reevaluation of public health strategies. If the connection is further substantiated, it could lead to the implementation of more rigorous screening programs, especially in regions with high infection prevalence. Such measures would aim to identify at-risk individuals early, allowing for timely intervention and treatment.
For individuals potentially at risk, recommendations include regular medical check-ups and discussions with healthcare providers about H. pylori testing. Lifestyle modifications, such as maintaining good hygiene practices and adhering to a healthy diet, may also help reduce infection risk. Public health campaigns to raise awareness about the symptoms and risks associated with H. pylori could play a vital role in prevention efforts.
Education and awareness are critical in mitigating the risks associated with H. pylori. By informing the public about the potential health implications of the infection, individuals can make informed decisions about their health and seek medical advice when necessary. This proactive approach could significantly impact the incidence of related health issues, including cancer.
Future Research Directions
While significant progress has been made, many questions remain unanswered about the relationship between H. pylori and cancer. Future research will need to explore the specific genetic and environmental factors that contribute to an individual’s susceptibility to cancer following infection. Understanding these variables could lead to the development of targeted prevention strategies.
Interdisciplinary research, combining insights from microbiology, oncology, and immunology, is essential for unraveling the complex interactions between H. pylori and cancer. Collaborative efforts between these fields could pave the way for breakthroughs in understanding the infection-cancer link and identifying potential therapeutic targets.
As research advances, there is hope for the development of new treatments or preventive measures based on a deeper understanding of H. pylori‘s role in cancer. Whether through vaccines, novel therapeutic agents, or lifestyle interventions, the findings from ongoing studies could significantly impact public health and reduce the global burden of infection-related cancer.